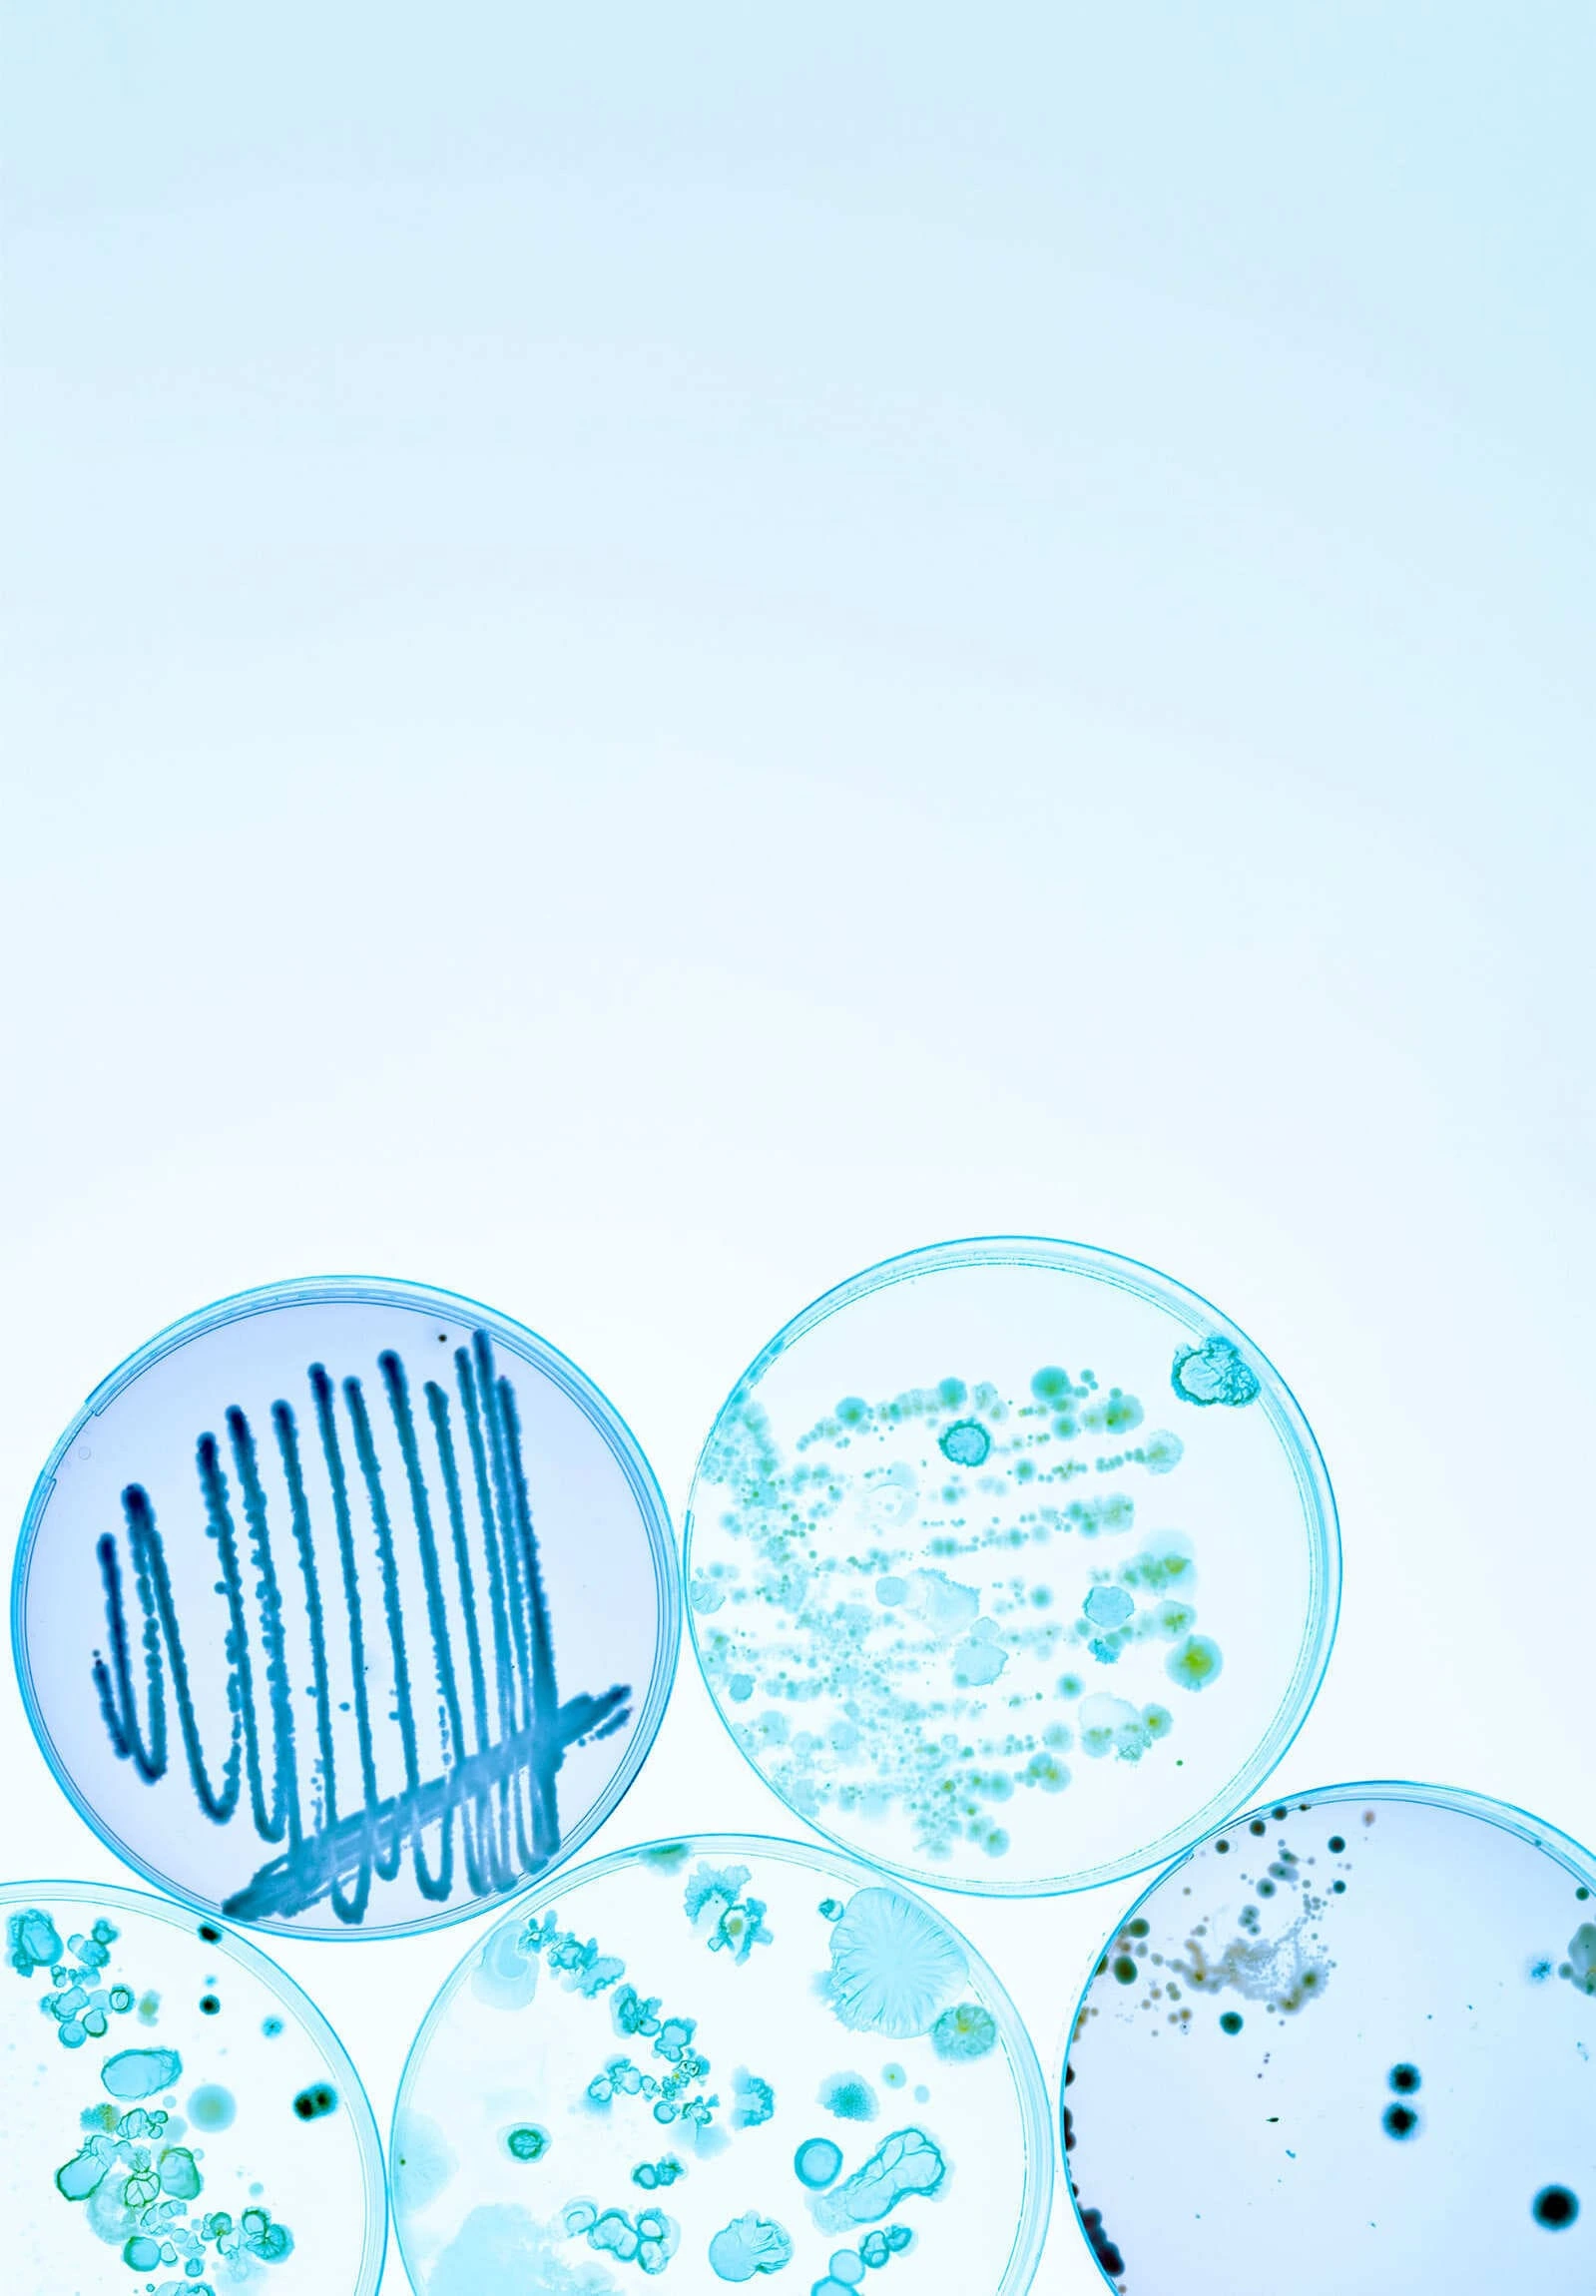
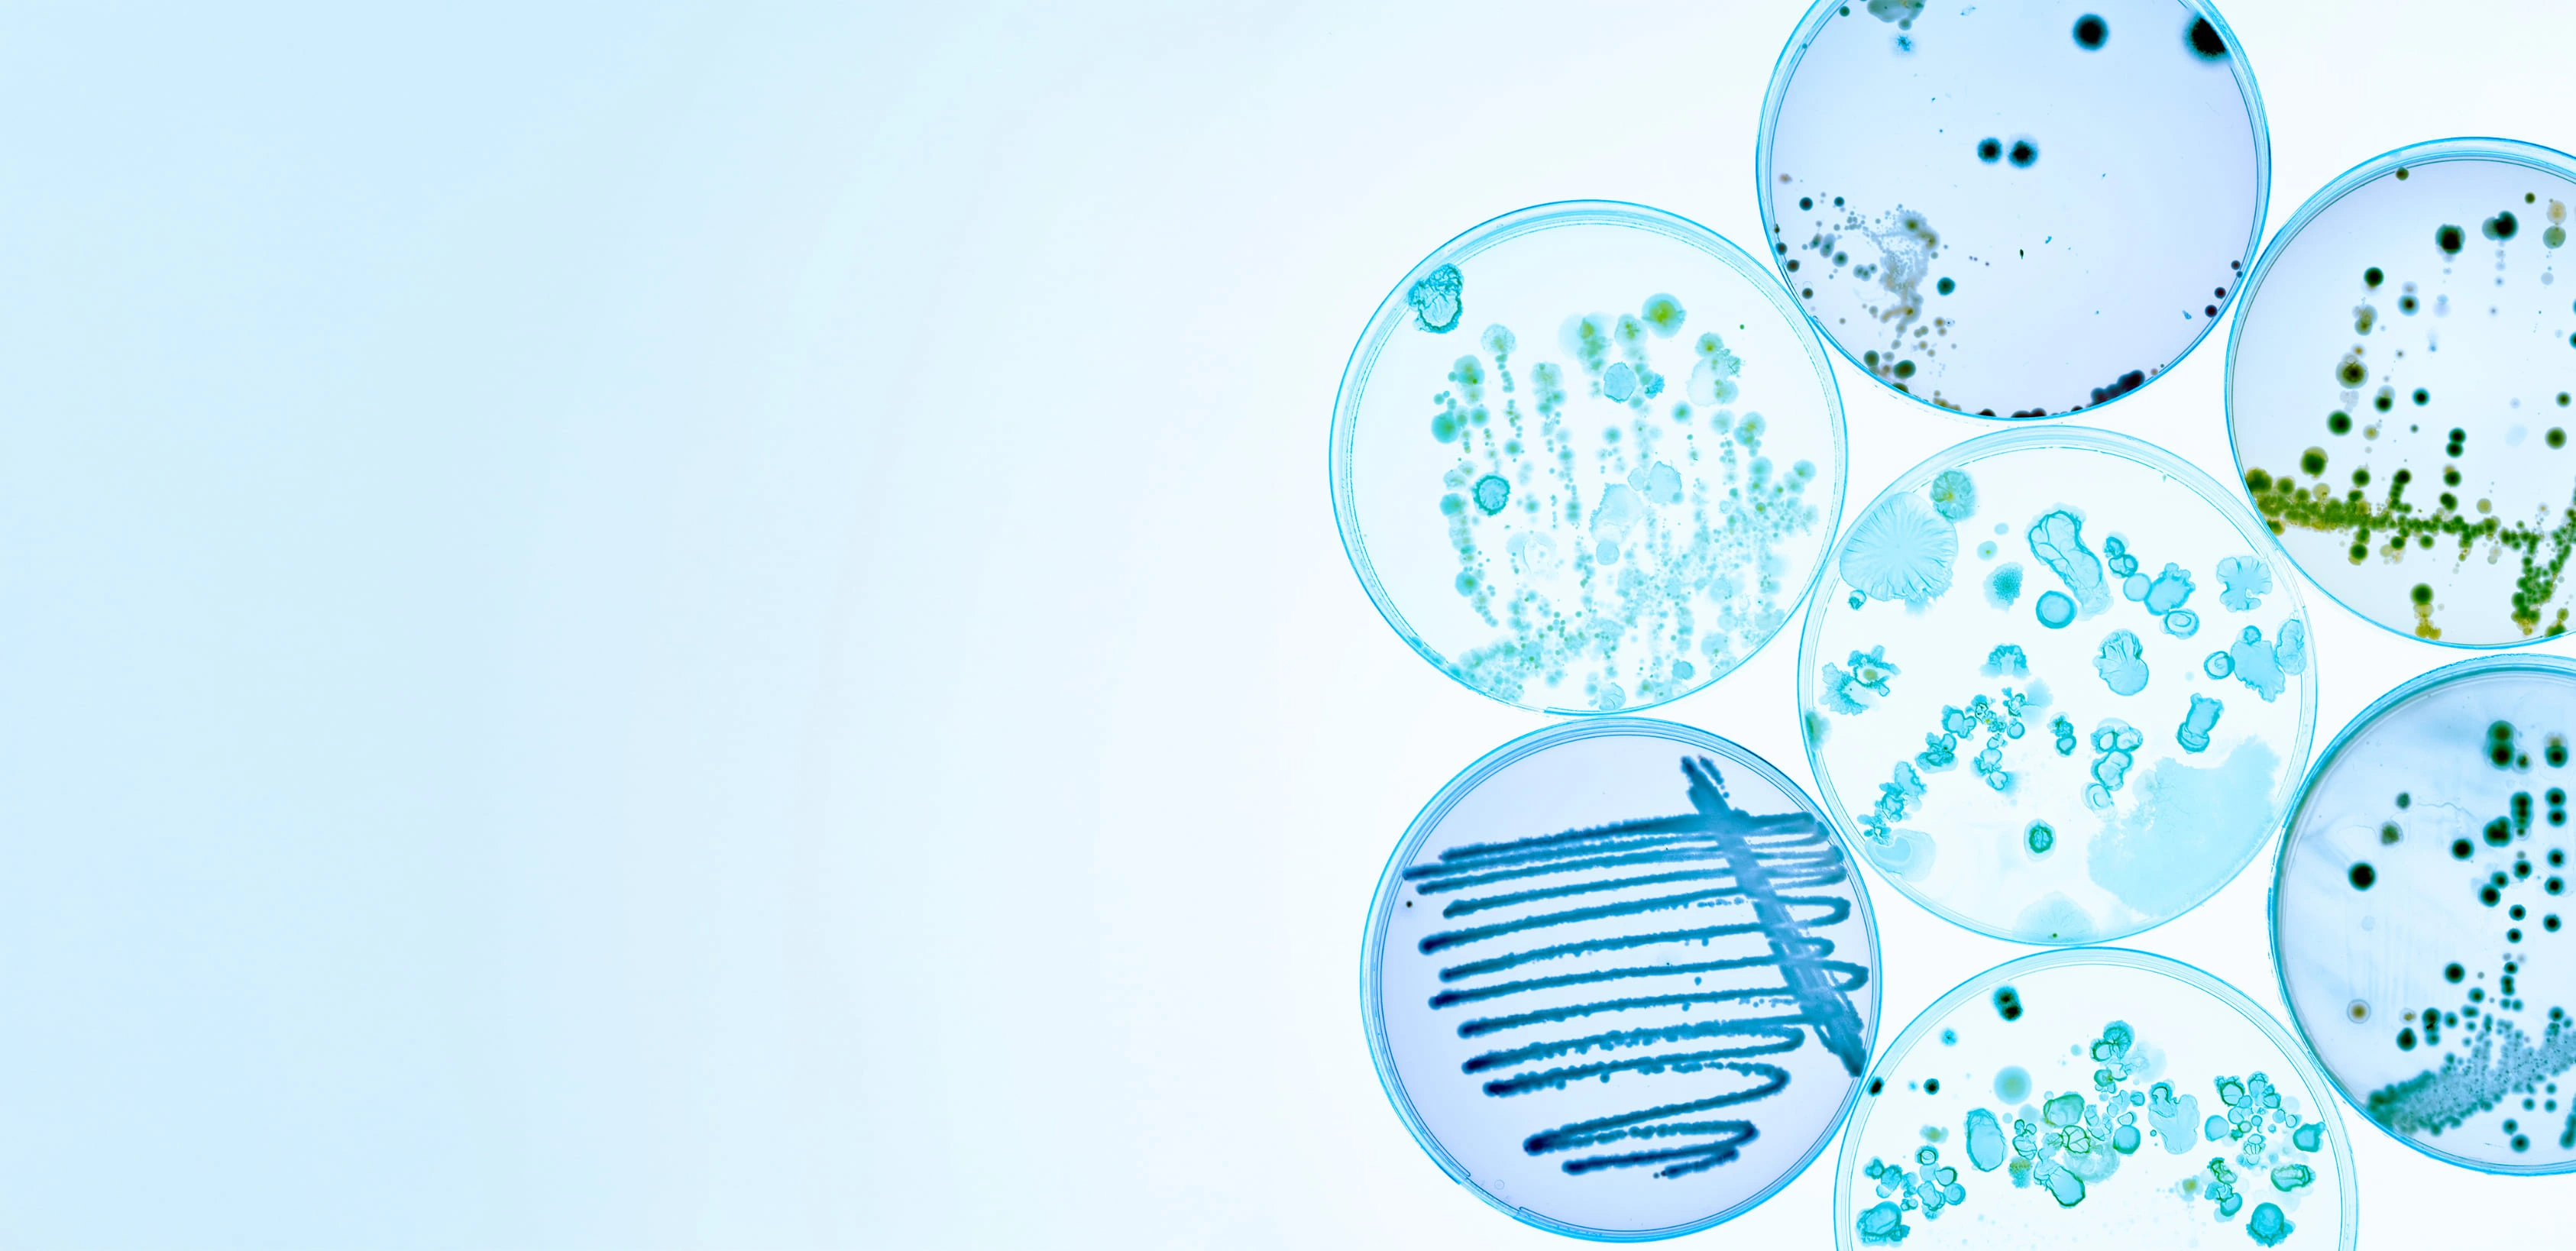
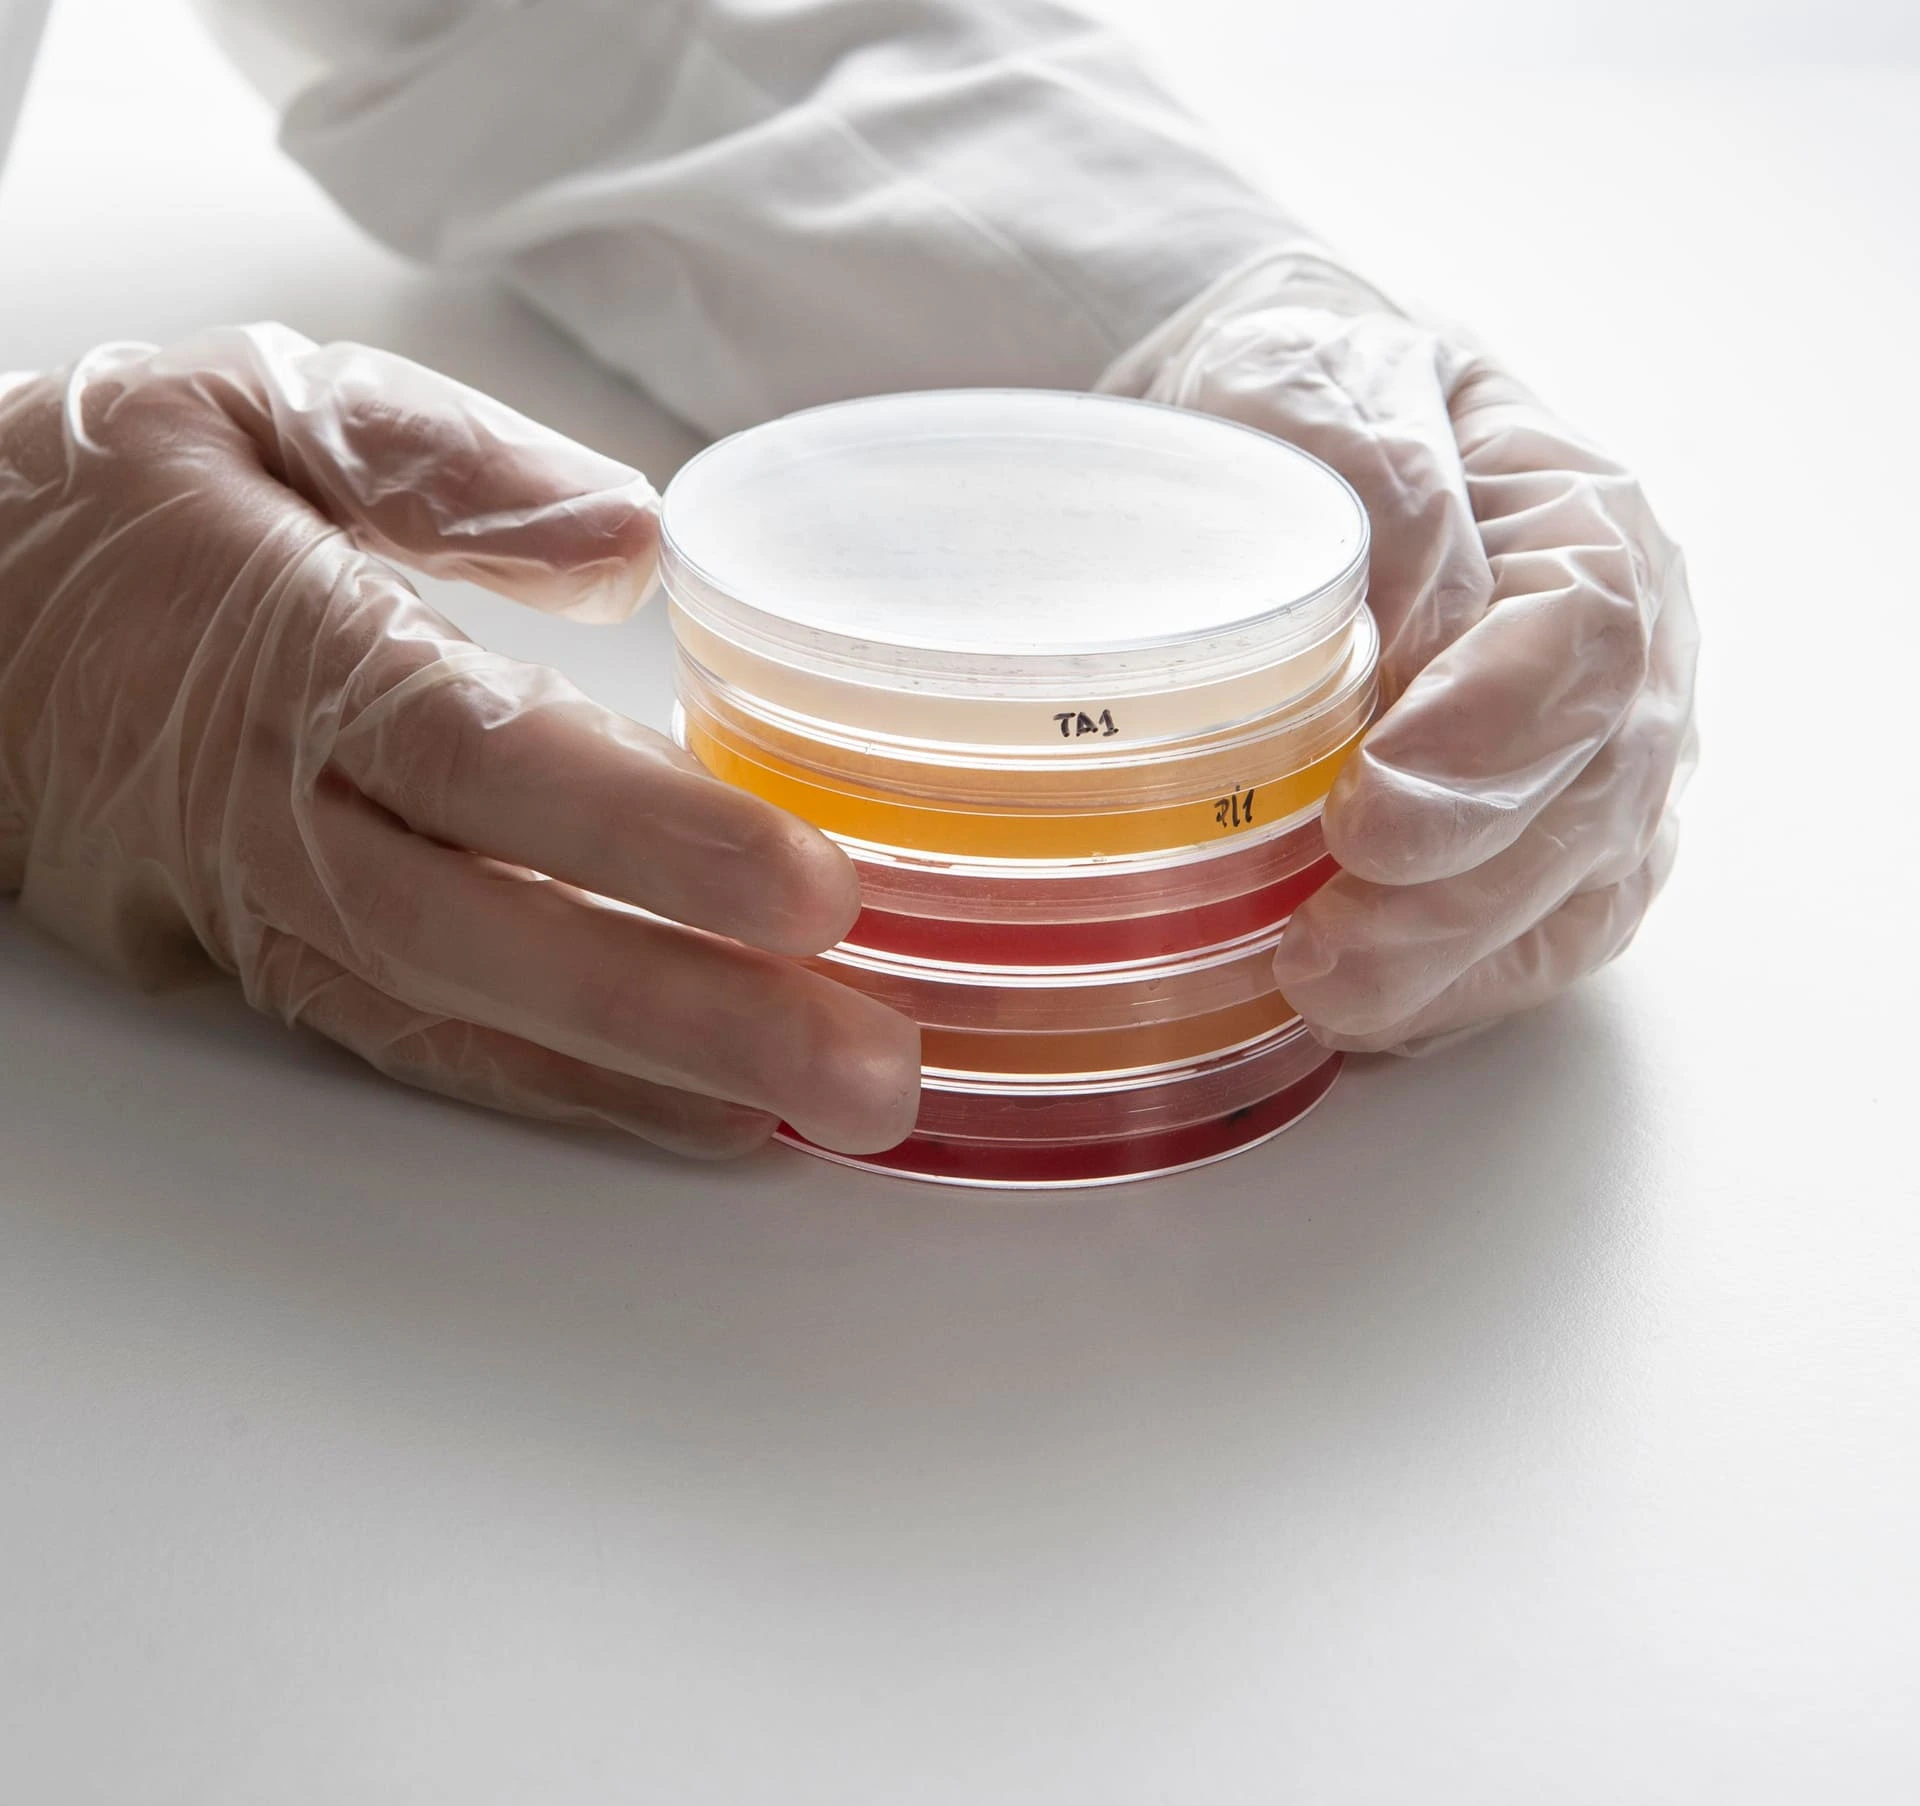
LA R&D au cœur de notre ADN
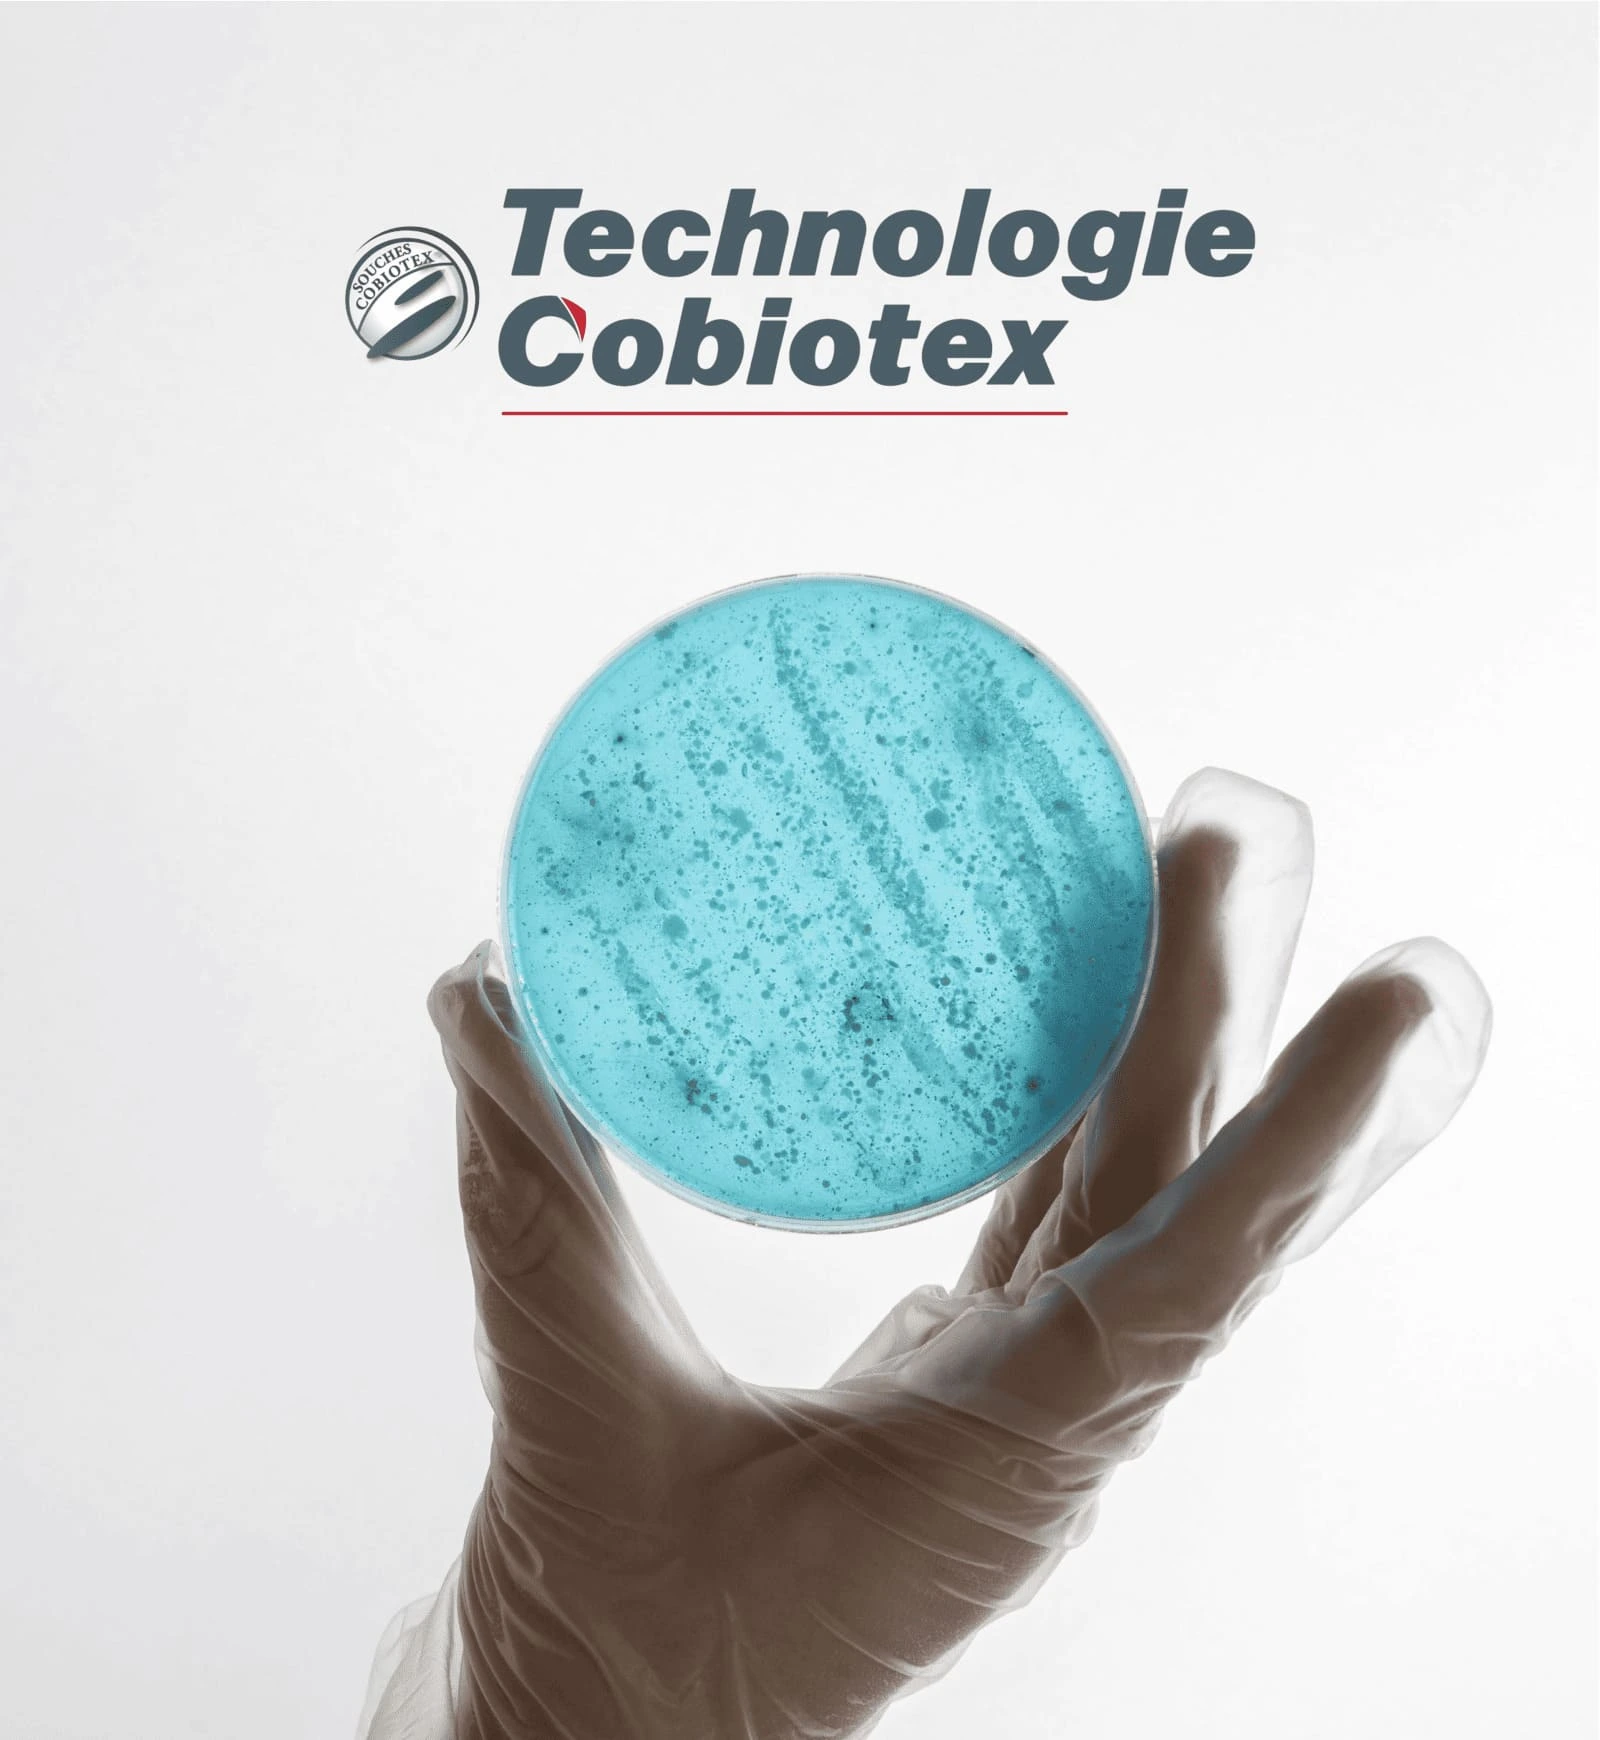
Les technologies Cobiotex

Développer
des solutions
bactériennes
éco-performantes
LA R&D au cœur
de notre ADN
Créé en 2005 et situé près de Bordeaux, notre laboratoire de recherches scientifiques est spécialisé dans la sélection, l’association, la production et la commercialisation de souches bactériennes. Nous intervenons dans des domaines clés tels que la biosécurisation animale, la bioremédiation des effluents et la biostimulation végétale.
Agréé CIR depuis 2011, notre laboratoire est également certifié ISO 22000, garantissant ainsi la sécurité alimentaire de nos produits. Notre expertise soutient l'innovation durable dans le secteur de l'agriculture et de l'élevage.

4
brevets
d’invention
+ 25
souches
déposées
Une souche Bacillus ISB06 agréée Substance Active BIOCIDE (TP3 – Hygiène vétérinaire) :
Unique en Europe (Règlement UE N°528/2012)
Détenteur d’une AMM produit Biocide (COBIOFILM+) pour l’hygiène des batiments d’élevage
Premier Biocide Bactérien Européen en catégorie TP3 – Hygiène vétérinaire
Détenteur d’une AMM biostimulant végétal
(souche Bacillus ISB05)
Notre vision
Développer des solutions bactériennes éco-performantes en agriculture pour réduire l’impact environnemental des productions, baisser la pression sanitaire en élevage et améliorer l’efficacité des cycles de l’azote et du carbone.

BIOSTIMULATION
des végétaux

BIOREMEDIATION
des effluents polluants

BIOPROTECTION
sanitaire des animaux, végétaux et produits alimentaires
Notre expertise
Les technologies Cobiotex
Nos technologies avancées permettent la formulation adaptée de complexes bactériens. Elles assurent ainsi une implantation optimale. Grâce à une sélection et une combinaison précises des souches, ces solutions s’adaptent parfaitement à chaque environnement ou niche écologique. Toutes nos souches font l'objet d'une caractérisation approfondie, tant sur le plan phénotypique que génotypique, garantissant une maîtrise de leurs propriétés.
Capacité d’inhibition
Baisse de la pression sanitaire
Mécanismes d'inhibition mis en place par les bactéries Cobiotex contre les microorganismes pathogènes du milieu.
Compétition spatiale & capacité d’adhésion
Garantie d'implantation
Adhésion des souches Cobiotex sur différents supports même les plus difficiles tel que l'inox (essai in vitro).
Compétition nutritive avec la flore bactérienne de l’environnement
Garantie de colonisation
Compétition grâce aux équipements enzymatiques et à la capacité de colonisation de nos bactéries.
Domaines d’application
Production animale
Production végétale
Nos activités
Nos domaines
d’activité
Nous mettons la biotechnologie au service de solutions vivantes et durables

Recherche & développement
Formulation & production
Prestations de services
Homologation
Gestion d’essais terrain
Formations techniques & scientifiques
Notre réseau
Notre laboratoire s'engage au quotidien pour développer notre écosystème scientifique.
Découvrez nos partenaires avec qui nous collaborons étroitement pour développer notre expertise.
Le groupe Teraxion
Une filiale du groupe Teraxion
Découvrez les filiales de notre écosystème, des entités clés qui apportent leur expertise, renforçant ainsi notre offre et la qualité de nos solutions.


Laboratoire de recherche scientifique du groupe Teraxion


Expert de la nutrition et hygiène animale


Spécialiste en biosolutions pour la croissance des plantes














